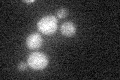
YNR015W
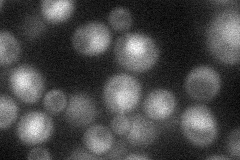
YNR015W
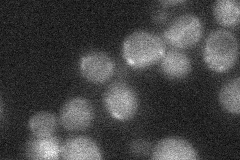
YNR015W
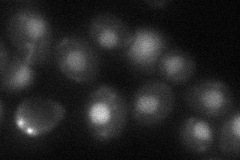
YNR015W

View description
Dihydrouridine synthase, member of a family of dihydrouridine synthases including Dus1p, Smm1p, Dus3p, and Dus4p; modifies uridine residues at position 20 of cytoplasmic tRNAs
Localization:
Intensity:
Fold change:
Significance:
-
C’ GFP library in SD
below threshold18.18 -
N' NOP1pr-GFP in SD
cytosol,nucleus32.6856 -
N' TEF2pr-mCherry in SD

below threshold9.52355 -
N' NATIVEpr-GFP in SD
below threshold24.4761 -
N' TEF2pr-VC and Cyto-VN in SD
nucleus38.4148 -
C’ GFP library in SD+DTT

punctate15.370.84No -
C’ GFP library in SD+H2O2

cytosol17.590.96No -
C’ GFP library in Starvation Media

cytosol22.191.22No -
C’ GFP library on the background of Pup2-DaMP

below threshold -
C’ GFP library on the background of CCT mutant

below threshold18.46521.01507No
